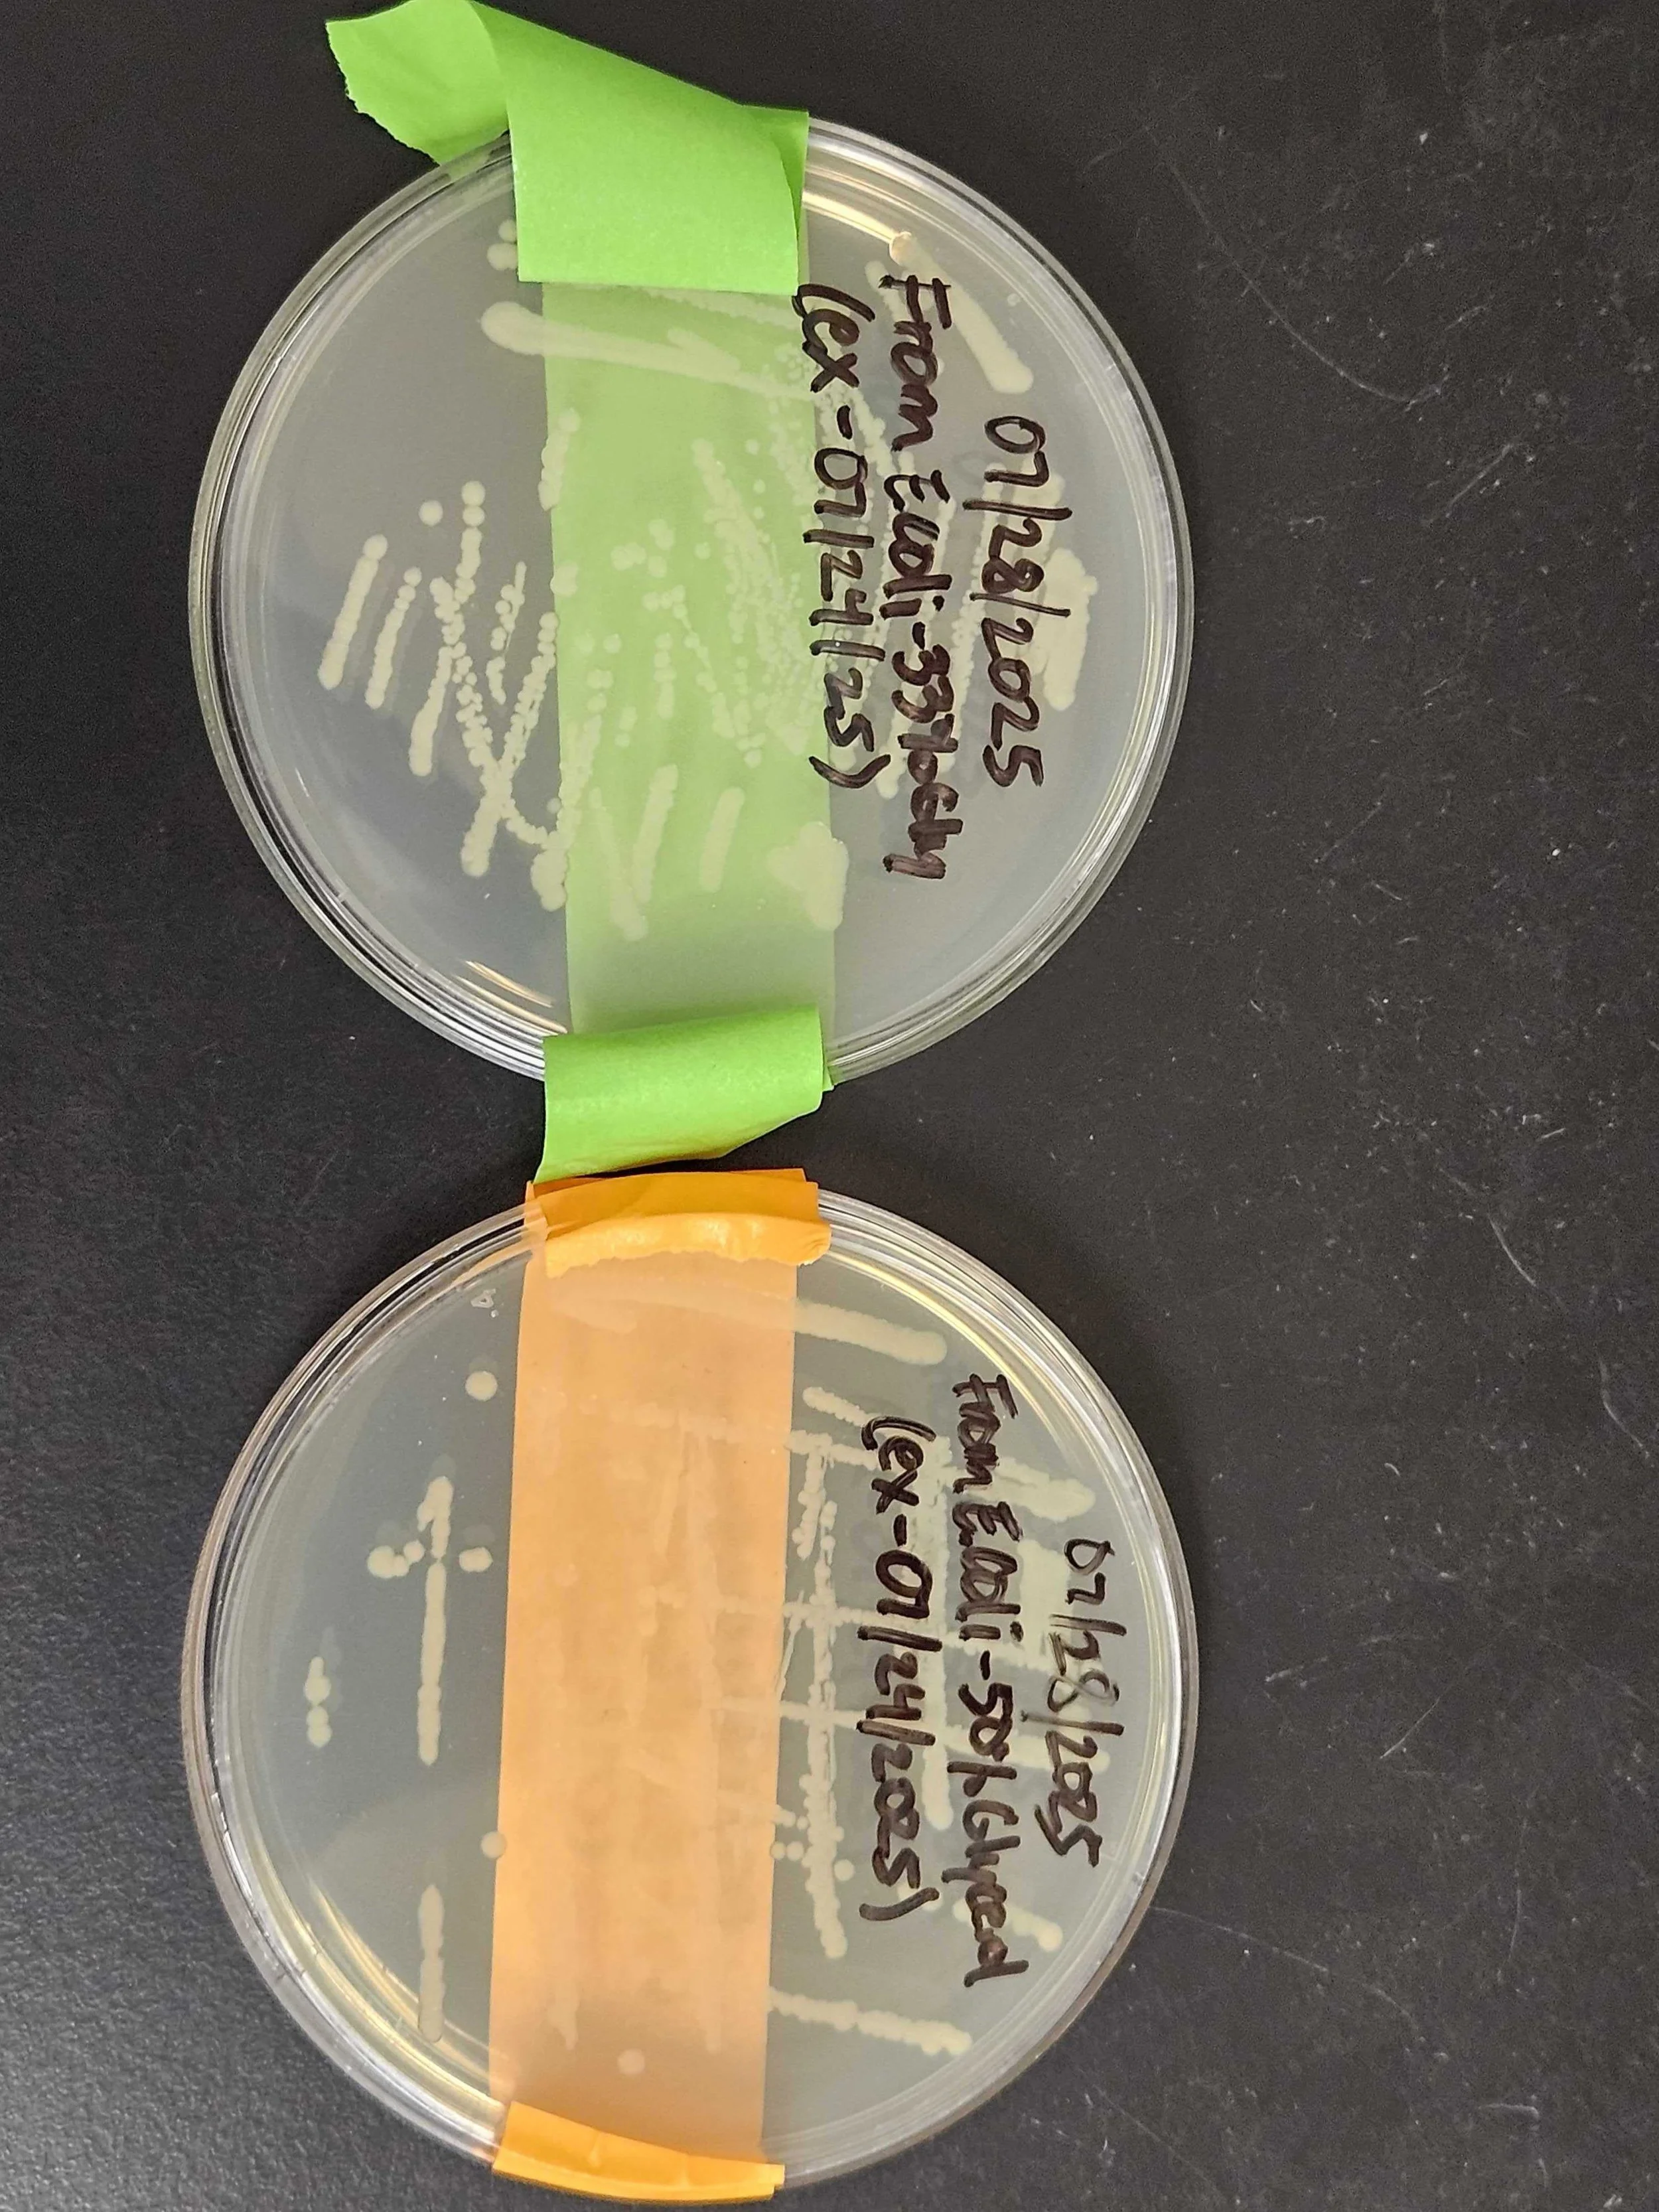

Narayanan Lab News 📰
-

Jan 17, 2026: The fearless Narayanan Lab members join ORCA and the Florida Department of Environmental Protection to remove sweetgum from Paynes Prairie! Avengers, assembled!
-
Jan 13, 2026: Congratulations to Syarif for getting selected to UF’s Emerging Scholar Program!
-

Dec 18, 2025: Sumeet represents Narayanan Lab at SPSI Macro 2025. He received the best poster award! Congratulations, Sumeet!
-

Dec 5, 2025: Narayanan Lab Holiday Party at Cypress and Grove. White elephant disputes yet to resolve!
-

Nov 7, 2025: New Group Photo is up! Many new faces!
-

Oct 20, 2025: Narayanan Lab welcomes new graduate students Amelia and Ratna to the group!
-

Oct 16, 2025: Aaron wins third prize in UF Chemistry's Annual undergraduate Chemistry Research Showcase!
-

Oct 14, 2025: Amal visits Henkel for SSAT 2025. Exciting times for adhesives and coatings.
-

Sep 12, 2025: Start of the Fall Pool Party!
-

Aug 20, 2025: Sarah becomes the best TA of Chemical Biology Division!
-

Aug 14, 2025: Sarah and Shradha represents at 1st SouthEast Amyloid-CONdensate (SEACON) symposium.
-

Jul 30, 2025: We have officially become a bunch of “okay” engineers!
-
Jul 28, 2025: We got some WT bacteria! Biofilms, prepare to get removed!
-

Jul 27, 2025: Aishwarya Deshpande becomes the lab’s first official alumnus. Aishwarya interned with us over the summer. Did I say she won the best poster award?
-

Jul 15, 2025: The starbucks cup saves the day on rheology.
-

Jun 12, 2025: Muskan wins the William & Arlene Ruegamer Scholarship!
-

Jun 10, 2025: Aadhya gets selected as Michelin Science Scholar!
-
Jun 6, 2025: Narayanan Lab discovers tubing at Gennie Springs
-

May 21, 2025: The lab assist with taking molecular mania to Talbot elementary.
-

Apr 28, 2025: High school students visit Narayanan Lab as a part of UF pre-college outreach event.
-

Apr 12, 2025: Aryan gets selected as CLAS University Scholar!
-
Mar 20, 2025: Narayanan Lab goes to Gilchrist Blue Springs
-

Mar 14, 2025: The synthesis crew is set for some magic columns!
-

Mar 12, 2025: The cell culture space is set up and ready to go (EHS approved!)
-

Feb 28, 2025: Recruitment weekend special
-

Feb 4, 2025: High school students from all over Florida visit the Narayanan Lab as a part of their JSHS competitions.
-
Jan 31, 2025: The first Narayanan Lab potluck!
-

Jan 20, 2025: All are suited up and ready for experiments!
-

Jan 15, 2025: Suited up and ready to go!
-

Dec 6, 2024: More packages! Cell culture begins!
-

Dec 2, 2024: First gen of Narayanan Lab has been assembled. Great science coming to you soon!
-

Oct 28, 2024: Prof. Frank Bates visits UF. Fun times for block copolymers at UF.
-

Sep 11, 2024: Narayanan Lab confocal microscope is ready to go! Exciting times for imaging enthusiasts!
-
Sep 4, 2024: We got some “small” packages
-

Aug 14, 2024: Narayanan Lab Opens its doors